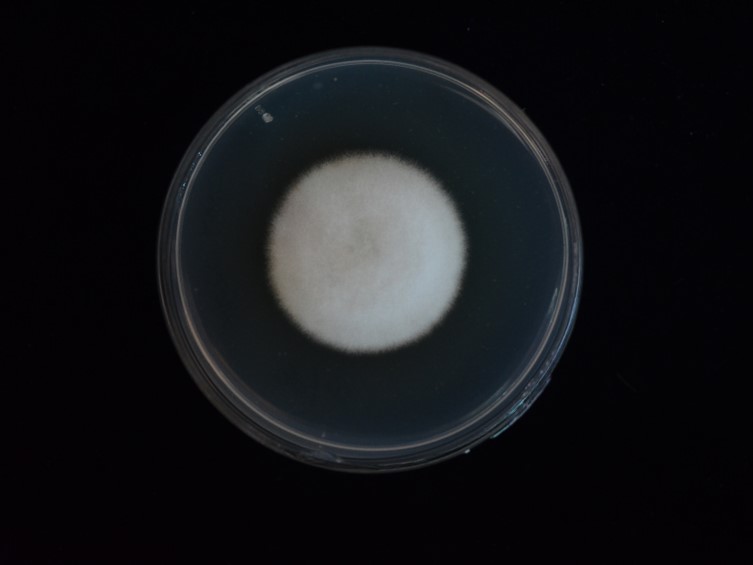

Holotype:
THAILAND, Kanchanaburi Province, Thung Yai Naresuan Wildlife Sanctuary, 11 Dec. 2007, K. Tasanathai, S. Mongkolsamrit, B. Thongnuch, holotype BBH 23823, ex-type living culture BCC 28816.
Habitat:
Underside of leaf.
Host:
Adult moths (Pyralidae; Lepidoptera).
Description:
Adult moth attached on the undersides of dicotyledonous leaf covered by white to cream mycelium.  Stroma arising from host body and wings, white to cream, cylindrical.
Stroma arising from host body and wings, white to cream, cylindrical.  Perithecia superficial, crowded at the tip of stroma or growing directly from mycelium that covers the host body, few to numerous, ovoid to obpyriform, 290-650 × 150-340 μm.
Perithecia superficial, crowded at the tip of stroma or growing directly from mycelium that covers the host body, few to numerous, ovoid to obpyriform, 290-650 × 150-340 μm.  Asci cylindrical, the bottom of asci thicker than the middle part, 170-360 × 2-4 μm.
Asci cylindrical, the bottom of asci thicker than the middle part, 170-360 × 2-4 μm.  Ascospores hyaline, filiform, multi-septate, discharged into part-spores, 5-12 × 1 μm.
Ascospores hyaline, filiform, multi-septate, discharged into part-spores, 5-12 × 1 μm.
Culture characteristics:
Colony on PDA growing with a diam of 23–28 mm in 14 d, white, circular, flat, entire. Colony reverse pale yellow at the center. Conidia and reproductive structures not observed.
Colony on PDA growing with a diam of 23–28 mm in 14 d, white, circular, flat, entire. Colony reverse pale yellow at the center. Conidia and reproductive structures not observed.
Reference:
Aini AN, Mongkolsamrit S, Wijanarka W, et al. (2020). Diversity of Akanthomyces on moths (Lepidoptera) in Thailand. MycoKeys 71: 1–22.
DOI: http://doi.org/10.3897/mycokeys.71.55126Species |
Strain |
Compound |
Pubchem CID |
Biological activity |
Reference |
|---|
|
Strain |
ITS | LSU | RPB1 | RPB2 | TEF1 |
|---|---|---|---|---|---|
| BCC 28816 | MT356080 | MT356091 | MT478000 | MT478007 | MT477982 |
| BCC 29197 | MT356083 | MT305694 | MT478003 | MT477991 | MT508840 |
| BCC 32191 | MT356081 | MT356092 | MT478001 | MT477989 | MT477983 |
| BCC 40869 | MT356082 | MT356093 | MT478002 | MT477990 | MT477984 |